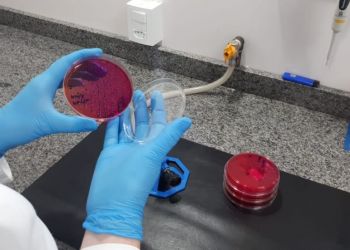
4

Sanuvitas Laboratórios amplia seu escopo de acreditação junto ao INMETRO
O Sanuvitas Laboratórios ampliou seu escopo de acreditação junto ao INMETRO, de 11 ensaios para 74 ensaios acreditados.
Em vista disso, buscaram a certificação junto a Rede Metrológica do RS com o objetivo de oferecer aos seus clientes e parceiros oportunidades de subsídio na realização dos ensaios.
Em vista desta certificação, o Sanuvitas em parceria com o Bônus Metrologia, oferece 60% de desconto na realização dos ensaios que fazem parte do escopo de acreditação do INMETRO (clique aqui e acesse o escopo completo).
Esse subsídio pode ser utilizado por empresas que:
- Tem faturamento de até 4 milhões e 800 mil por ano;
- Tem cadastro junto ao SEBRAE. O cadastro é rápido e gratuíto, basta ligar para 0800 570 0800.
OBS: O valor disponibilizado via Bônus Metrologia é de mínimo R$100,00 e máximo de R$5000,00 por ano/cliente.
Este subsídio está disponível para todos os Ensaios de seu escopo. Abaixo alguns dos ensaios que fazem parte das monitorias rotineiras de granjas e que estão disponíveis no subsídio de 60%:
- Salmonella;
- Ensaios microbiológicos em águas;
- Plaqueamento ambiental;
- Ensaios sorológicos de doenças das aves por ELISA: lanringotraqueíte, bronquite, pneumovírus, anemia, etc.
- Dentre vários outros patógenos de importância sanitária e de segurança alimentar: enterobacteriacea, tipificação de salmonela PNSA, campylobacter, etc.
Para mais informações, acesse www.sanuvitas.com.br, ou pelo telefone (54) 3462.2195.
Garibaldi/RS - 03/03/2021

Contato
Área Restrita